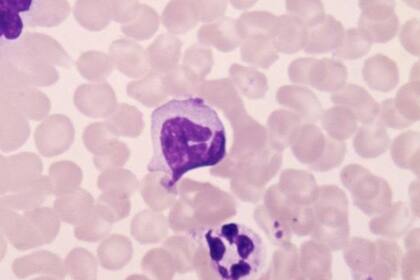
Los protagonistas de la respuesta inmunitaria adaptativa son los linfocitos, capaces de generar anticuerpos y memoria inmunológica

1 minuto de lectura'

Las diferentes características de nuestra respuesta inmune según la edad sugieren que debemos apostar por varias vacunas contra el SARS-CoV-2 en lugar de por una sola.
La respuesta inmune contra los virus consiste en una serie de eventos en cascada que van escalando si el organismo no es capaz de controlar la infección rápidamente.
Primero, se moviliza el sistema inmunitario innato, cuyos representantes mayoritarios son los macrófagos, que desarrollan el mismo tipo de respuesta independientemente del agente infeccioso.
Si no es suficiente para acabar con el patógeno, se moviliza el sistema inmunitario adaptativo o adquirido, mucho más sofisticado y dependiente del tipo de bacteria o virus. Los protagonistas de la respuesta inmunitaria adaptativa son los linfocitos, capaces de generar anticuerpos y memoria inmunológica.
Una vez que una persona ha pasado una infección, en su cuerpo quedan aproximadamente 100 linfocitos de memoria, que rondarán en la sangre y órganos, desarrollando inmediatamente una respuesta inmune específica si la persona vuelve a ser atacada por el mismo patógeno.
Estas células de memoria van muriendo con la edad, más aceleradamente si la persona está sometida a estrés o a enfermedades crónicas.
A medio camino entre la inmunidad innata y la adquirida se encuentran dos tipos de células inmunes: las gammadelta (?d) y las Natural Killer o NK.
Estas células, aunque son inespecíficas y capaces de responder ante cualquier atacante, pueden desarrollar memoria respecto a los patógenos a los que han atacado.
Los macrófagos, ?d y NK no reconocen una proteína específica del patógeno, sino más bien patrones moleculares de daño o estrés celular.
Por el contrario, los linfocitos responden a una determinada proteína del patógeno.
En los seres humanos existe una preponderancia del sistema inmune innato en niños (que aún no han desarrollado la inmunidad adaptativa) y ancianos (en los cuales esta se va "extinguiendo").
En este aspecto, una vacuna desarrollada contra una proteína concreta de un virus debería generar una respuesta inmune más robusta en jóvenes y adultos, mientras que una vacuna contra el virus completo podría ser más efectiva en niños y ancianos.
Mejor aportar que competir
A fecha de 16 de junio de 2020, el portfolio de vacunas en desarrollo contra el covid-19 es de 163, encontrándose en diferentes estados de desarrollo. La mayoría de estas vacunas han empleado una de las estrategias mostradas en la figura 1.
En este momento 10 vacunas están siendo probadas en fases clínicas.
Los requerimientos de cada una de las fases (figura 2) garantizan la eficacia y la seguridad de las candidatas y se encuentran reguladas por normas de la Agencia Europea de Medicamentos (EMA, por sus siglas en inglés), la Organización Mundial de la Salud (OMS) y la Administración de Medicamentos y Alimentos de Estados Unidos (FDA, por sus siglas en inglés).
Una de las más avanzadas es la de Moderna, basada en el ARN mensajero que produce la proteína spike (S) del SARS-CoV-2, responsable de la entrada en nuestras células mediante la unión con el receptor ACE-2 (enzima convertidora de angiotensina 2).
Otra de las vacunas es la desarrollada por la Universidad de Oxford, ChAdOx1 nCoV-19. Esta vacuna utiliza una versión atenuada de un virus que no es dañina para el ser humano pero causa infecciones en chimpancés, y ha sido modificada genéticamente para producir la proteína S del coronavirus.
Cansino Biological está desarrollando una vacuna parecida a la anterior, AD5-nCoV, que utiliza un virus no replicante que causa el resfriado común. Este vector transporta el gen de la proteína S de la superficie del coronavirus, con la cual se intenta provocar la respuesta inmune para combatir la infección.
Por último, Sinovac Biotech está desarrollando la vacuna PiCoVacc, que utiliza el virus SARS-CoV-2 inactivado químicamente.
Por qué necesitamos un pódium compartido
En vista de lo anterior, el enorme esfuerzo realizado por investigadores y farmacéuticas para encontrar una vacuna eficaz contra COVID-19 no debe ser una carrera con un solo ganador.
El propio desarrollo de la enfermedad, compartido por otros SARS, provoca una exagerada potenciación de la respuesta inmune en individuos con un sistema inmunológico desgastado o menos eficiente (prevalencia de respuesta innata).
Sin embargo, una vacuna, para que sea eficaz por un tiempo prolongado, debe desarrollar en el organismo una respuesta adaptativa, mayoritariamente la generada en adultos, no ancianos.
Por eso, el abanico de vacunas que estará disponible en el futuro podrá abarcar distintos grados de eficacia y permitirá conseguir una inmunidad de grupo suficiente para minimizar la transmisión y proteger a los más vulnerables.
La mejor vacuna debería proteger al personal sanitario, a los adultos con comorbilidades, ser eficaz para niños y ancianos, minimizando el efecto inmunopotenciador, y de rápida y fácil producción y almacenamiento.
Disponer de varias opciones con distintas especificidades permitirá administrar la más adecuada según individuo y situación.
Factores como la estacionalidad y la diversidad geográfica, sanitaria y social han influido en la incidencia de la enfermedad y, por lógica, afectarán a la estrategia de la profilaxis.
En países tropicales se vacunaría en masa para proteger a la población más vulnerable.
Sin embargo, en países con climas templados, con incidencia estacional, se inmunizaría a la población de más riesgo en periodos de baja transmisión, como ocurre con la campaña anual contra la gripe.
Por tanto, necesitaremos todas las vacunas candidatas que vayan cruzando la meta, y estar preparados para los nuevos retos que, en salud global, quedan por llegar.
Otras noticias de Covid
1La fórmula infalible de Mirtha Legrand para estar espléndida a los 99 años
2Estos son los 6 peores alimentos para la salud intestinal, según especialistas
- 3
Bandas elásticas: el accesorio de fitness clave para fortalecer la masa muscular
4Hábitos alimenticios que dañan el cerebro, expertos revelan cómo mejorar la concentración






